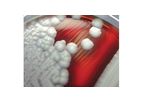
Bacterial Analysis

- Home
- Companies
Refine by
Industries served
- Monitoring and Testing
- Environmental
- Agriculture
- Water and Wastewater
- Soil and Groundwater
- Health and Safety
- Chemical & Pharmaceuticals
- Air and Climate
- Energy
- Manufacturing, Other
- Food and Beverage
- Construction & Construction Materials
- Medical / Health Care
- Waste and Recycling
- Oil, Gas & Refineries
- University / Academia / Research
- Plastics & Resins
- Textile
- Automobile & Ground Transport
- Aerospace & Air Transport
- Packaging
- Government
- Defense
- Paint
- Pulp & Paper
- Mining
- Metal
- Maritime/Shipbuild/Water Transport
- Electronics and Computers
- Forestry & Wood
- Banking & Finance / Insurance / Legal
- Dry Cleaning
- Domestic
- Glassware
- Retail
- Printing
- Real Estate
Environmental Industry Laboratory
221 companies found

Laboratorybased inNorthwood, OHIO (USA)
NAMSA is medical research organization providing expert regulatory, laboratory, clinical, and compliance services to medical device and healthcare product manufacturers. At every stage of the product development process, we provide strategic ...
Environmental monitoring is performed to meet the requirements of quality system regulation when such an environment can influence the pre-sterilization bioburden level or resistance on a medical ...

Laboratorybased inCochin, INDIA
SciGenom is an ISO certified company, with a fully functional state-of-the-art molecular biology laboratory in Cochin. Its R&D lab is recognized by Department of Scientific & Industrial Research (DSIR), Ministry of Science & Technology, Government ...
The molecular cloning team of SciGenom offers customized plasmid cloning services, and provides the finished ready-to-use DNA constructs. Currently, our service cater to the following molecular cloning ...
Laboratorybased inCleveland, OHIO (USA)
Water & Wastewater Laboratories, Inc. is a full service Analytical Laboratory that works closely with clents and their individual requirements. We started the business in 1973 and incorporated separately from our parent company in 1992. We have a ...
Laboratorybased inambala cantt, INDIA
we are globally reknowened co in the field of laboratory instruments since1980.we are manufacturers for human anatomy models and suppliers for physics,chemistry,bjology instruments in india,an iso 9001 certified ...

Laboratorybased inChatsworth, CALIFORNIA (USA)
American Analytics (AA) is a full service environmental analytical laboratory founded in 1980 by Mrs. Zvia Uziel. We are a State of California Department of Health Services certified environmental laboratory. American Analytics is also certified by ...
Mobile Laboratories provide fast, on site analysis for projects that require immediate results. American Analytics has two state certified mobile laboratories to serve your soil, water and vapor analyses needs with high quality, dependable service ...

Laboratorybased inlinkou dist. , TAIWAN
In the past 40 years, Yakos65 has been continuously and consistently providing our customers a myriad of high quality laboratory products including Biological safety cabinet, Flammable safety cabinet and Zebra Fish Housing System. All our products ...
Laboratorybased inMississauga, ONTARIO (CANADA)
Mold & Bacteria Consulting Laboratories (MBL) specializes in identification and enumeration of mold and bacteria commonly detected in air, fluids and bulk samples collected from homes, schools, offices, hospitals, industrial, agricultural, and other ...
The samples discussed above (with the exception of tape-lift and non-viable air samples) can all be analysed for culturable bacteria. We can also test water samples. Since virtually every sample has some form of bacteria, it is important to have a ...

Laboratorybased inRochester, NEW YORK (USA)
Paradigm Environmental Services, Inc. is a full-service company certified and equipped to perform accurate, high quality analyses in environmental chemistry, asbestos, and lead-based paint. We are experienced in studying a wide range of materials to ...
Paradigm has highly qualified analysts in multiple lab locations, with an array of dedicated Polarized Light Microscopes (PLM) and Transmission Electron Microscopes (TEM). With our ELAP and NVLAP certifications we are prepared to address your ...

Laboratorybased inLos Angeles, CALIFORNIA (USA)
Pacific Coast Analytical Services (PCAS) has been providing analytical and consulting services for more than 15 years to the environmental, food and chemical industries. From the first enterprise as a chemical laboratory, PCAS has grown into a state ...
Laboratorybased inPANCHKULA, , INDIA
An ISO 9001:2008 certified company, we are making great strides in the clinical, scientific, laboratory and pharmaceutical instruments industry. All our instruments have been certified by the ISO : 9001: 2008 adding credibility to our name. We ...
2 CELL HOLDER - Range 190-1100 nm, basic/quantative wavelength scan/DNA Protein Test/Kinetic, automatic peak picking & spectrum display. Large screen with graphic display. Spectrum and data can be printed out by printer and sent to computer via ...

Laboratorybased inCranston, RHODE ISLAND (USA)
ESS is a full service analytical laboratory that is dedicated to providing engineering consultants, industry and government with high quality analytical data and superior customer service. We pride ourselves on our reputation of providing accurate ...
Coliform, Alkalinity, Hardness, Chloride, Fluoride, Iron, Lead, Manganese, Nitrate, Nitrite, pH, Specific Conductance, Sulfate, TDS, Turbidity, VOC ...

Laboratorybased inHillside, NEW JERSEY (USA)
Garden State Laboratories, Inc. is a certified independent water, food and environmental testing laboratory. We analyze drinking water, wastewater, sludges, biosolids, soils, solid wastes, hazardous wastes, monitoring wells, food and dairy products ...

Laboratorybased inDubai, UNITED ARAB EMIRATES
Geoscience is a UAE based private independent testing laboratory established in 1996. The laboratory is fully owned by UAE national Mr. Abdul Laif Ali al Gargawi. Currently GTl is one of the fully equipped laboratories capable to perform Physical, ...
GTL provides Halal assurance to industry and consumers. The tests will work on the principle of identity preservation, where all ingredients can be traced back to their source, maintaining supply chain integrity making its halal certification more ...

Laboratorybased inDulles, VIRGINIA (USA)
Our services include a complete range of sampling and analysis of indoor environments for bioaerosols, and the identification of biological sources of IAQ problems. In addition to a full range of microbial culture analysis, our microbial services ...
We offer a full menu of viable bacteria (HAI pathogens, MRSA, Mycobacterium and environmental bacteria) and viable fungi (Aspergillus, Penicillium, Cryptococcus, Stachybotrys and environmental fungi). In addition to viable analysis we also offer a ...

Laboratorybased inMalvern, DELAWARE (USA)
Founded in 1996, LifeSensors, Inc. helps life scientists innovate in basic research, drug discovery and diagnostics. LifeSensors pioneered the SUMO-fusion system for high quality protein expression. Development of cutting-edge tools for ubiquitin ...
Laboratorybased inSandy Hook, CONNECTICUT (USA)
Willow Environmental, LLC. is a full service environmental testing company. Some of our services include: lead paint XRF inspections, mold and indoor air quality testing, asbestos inspections, radon testing, water testing, ...
Many building components may contain asbestos, such as insulation, floor tiles, mastic roofing, and sidings. When disturbed or damaged, asbestos can cause significant health threats. Willow is licensed and trained to inspect and obtain samples for ...

Laboratorybased inTianjin, CHINA
KMD Bioscience Co., Ltd. specializes in the research & development of Human Drugs. We are an ISO 9001:2015 certified company. We specialize in antibody discovery services, and gradually established stable cell line construction & screening, natural ...

Laboratorybased inNew Delhi, INDIA
ADVANCE INSPECTION & TESTING LAB (AITL) is a leading Delhi based test house having facilities and expertise comparable to national & international testing laboratories. The laboratory offers high quality & extremely cost effective Inspection & ...
Advance Inspection & Testing Lab with wide experience provide analysis of fabric and apparel to leading National & International standards which include specialized testing of Fibres/ Textiles and ...

Laboratorybased inGrass Lake, MICHIGAN (USA)
IBR provides instruments, systems, and testing services for the detection and analysis of particulate contamination and verification of filtration performance. We manufacture the world's most accurate particle counting systems specifically designed ...

Laboratorybased inChapeltown, UNITED KINGDOM
Far more than just a testing laboratory, Glass Technology Services have been helping companies for over 50 years to design, manufacture and bring glass products to market.From one off projects to long-term consultancy contracts, our team of leading ...
We are accredited by UKAS to ISO 17025 and the Environment Agency's MCERTs Monitoring Certification Scheme. All our site staff are fully trained in working at height and hold MCERTs level 2 certification. MCERTs accredited testing is a requirement ...